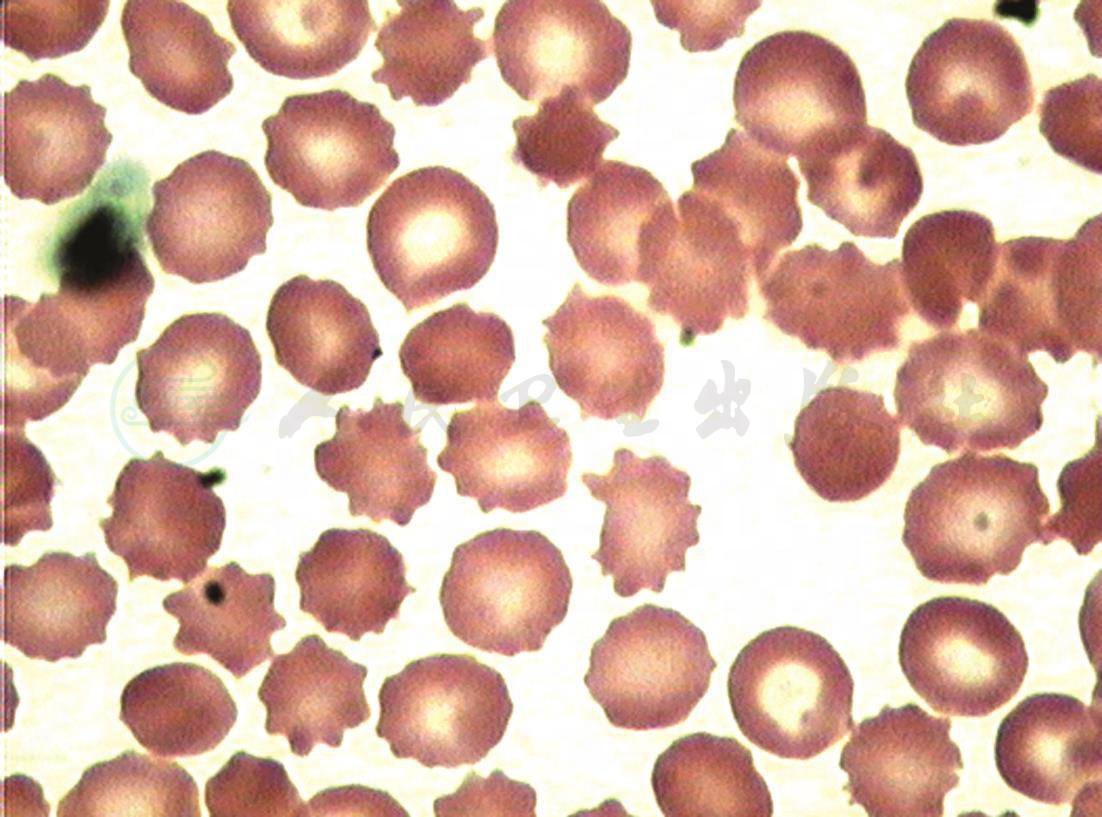

患者,男性,44岁,汉族,广东省佛山市人。
病史
主诉
反复咬舌、咬唇、构音障碍、肢体不自主运动2年。
现病史
患者于2年前食蟹后常出现不自主咬舌、咬唇、咬破口颊,造成口腔反复溃疡,以右颊多发。后常出现进食时咬破嘴唇及将食物推出口外,食物存留于齿颊之间,以右侧明显,进食时右侧咀嚼力弱,流涎,并渐渐出现构音障碍、吞咽困难,时有饮水呛咳,伴有耸肩、双手抖动、扮鬼脸等不自主运动,无粗大舞蹈样动作。行走时偶会出现右下肢力弱、欲倾倒现象,无右上肢乏力。不自主运动以精神紧张时加剧,休息后减轻,睡眠时并未消失。经当地医院诊治,口腔溃疡愈合,但其他症状反复发作。2001年在当地医院诊断为“右面瘫”,予“维生素”等药物及针灸治疗,言语不清似有改善,但不自主运动无缓解。因患者临床症状不影响工作未再诊。入院前10多天出现面部红斑,无痛无痒,再次当地医院就诊,予“氨酪酸”“氟哌啶醇”、“刺五加”等药物治疗后红斑消退,但其他症状无改善,为进一步诊治转入我院。起病以来,无发热、抽搐,无复视,无头痛,胃纳可,大小便正常,体重无明显下降。
既往史
平素健康状况良好。否认高血压、糖尿病、冠心病、脑卒中病史;否认肝炎、结核等传染病史;无手术、外伤、输血史。
过敏史
否认食物、药物过敏史。
个人史
原籍出生长大;否认到过疫区及疫水接触史,否认特殊化学品及放射线接触史。无烟酒等不良嗜好。
婚育史
适龄结婚,育有1女,配偶和女儿体健。
家族史
父亲约30岁死亡(死因不详);家族成员中未发现有类似疾病及遗传病史。
体格检查
一般情况
体温36.9℃,心率75次/分,呼吸18次/分,血压120/75mmHg。发育正常,营养中等,神志清楚,精神可,自主体位,查体合作。双颧部可见片状红斑,直径约2~3cm,左侧明显,余皮肤及黏膜无发绀、黄染、苍白,全身浅表淋巴结未触及。头颅五官无畸形,口腔黏膜光滑,无皮疹、无溃疡,咽无充血,双侧扁桃体无肿大。心、肺、腹、四肢及外生殖器未见异常。
专科情况
精神智能状态
查体合作,理解力、记忆力、定向力正常,计算力稍差,言语欠流利,精神、意识、行为无异常。
脑神经
无嗅觉缺失、过敏及倒错。视力、视野无异常,双眼底视乳头边缘清,A∶V=2∶3,动脉反光正常,未见动静脉压迹,视网膜未见出血、渗出。无眼裂增大或变窄,双眼睑无下垂,双眼球居中,无突出、凹陷,眼球各向运动无受限;双侧瞳孔等圆等大,直径约3.5mm,双侧直接、间接对光反射佳,调节、辐辏反射正常,无角膜K-F环。面部感觉对称存在,颞肌、咬肌无萎缩,咬牙有力,张口下颌无偏斜,角膜反射存在,下颌反射未引出。右侧额纹稍浅,右眼闭合不全,右侧鼻唇沟稍浅,露齿口角偏向左侧,鼓腮右侧漏气。听力粗测及音叉试验正常,无眩晕、耳鸣。软腭提升对称有力,悬雍垂居中,构音欠清、饮水呛咳、吞咽困难,咽反射存在。胸锁乳突肌、斜方肌无萎缩,转颈、耸肩对称有力。伸舌居中,无舌肌萎缩及舌肌震颤。
运动系统
右利手,肌肉无萎缩,四肢肌张力减低,肌力5级,未见共济失调,可见耸肩、右侧肢体小幅度不自主动作以及不自主咬舌、咬唇动作。
感觉系统
未见异常。
反射
腹壁反射正常,四肢腱反射消失。
病理反射
未引出。
脑膜刺激征
未引出。
自主神经系统
未见异常。
辅助检查
实验室检查
血液学
血常规
网织红百分率0.026%(参考值0.004%~0.019%),网织红计数136×109/L(参考值19~89)。
肝肾功能、血糖、血电解质均未见异常。
血生化
GOT 39U/L(参考值<37),CK 1216U/L(参考值25~200),CK-MB 49U/L(参考值<24),C3 0.69(参考值0.79~1.17),C4 0.14(参考值0.17~0.31)。
脂蛋白、血沉、ASO、类风湿因子、CRP、风湿系列、梅毒抗体、抗艾滋病抗体、血清铜蓝蛋白、血清铜、24小时尿铜、血管炎4项、感染5项均未见异常。
血促卵泡激素11.64IU/L(参考值1~8IU/L),黄体生成素14.67IU/L(参考值2~12IU/L),泌乳素28.78ng/ml(参考值1.61~18.77ng/ml),雌二醇、睾酮和孕酮均正常。
血、骨髓象细胞学
均符合棘红细胞增多症改变。
外周血涂片特征(图1):
(1)涂片、染色一般。
(2)未见有核红细胞,成熟红细胞中见棘形红细胞,其占比例为30%,该类细胞形态呈棘刺状,每个细胞有5~10个棘状突起,大部分细胞中心淡染区消失。
(3)粒细胞占74%,比例增高,形态大致正常。
(4)淋巴细胞占22%,比例、形态大致正常。
(5)血小板成簇分布。
(6)未见寄生虫。
骨髓片特征(图2):
图1 外周血涂片见棘形红细胞(×1000)

图2 骨髓涂片见棘形红细胞(×1000)
(1)取材一般,涂片尚可,染色可。
(2)骨髓有核细胞增生活跃,粒∶红=2∶1。
(3)红细胞占26%,比例偏高,以中晚幼红阶段为主,可见棘形成熟红细胞。
(4)粒细胞占53%,比例、形态大致正常。
(5)淋巴细胞占18%,比例、形态大致正常。
(6)单核细胞占2.5%,比例、形态大致正常。
(7)全片见巨核细胞13个,血小板成簇分布。
(8)未见转移癌细胞及寄生虫。
大、小便
大、小便常规未见异常。
脑脊液
脑脊液常规、生化、细胞学未见异常。
影像学检查
胸片
未见异常。
头颅MRI+MRA
脑MRI平扫见双侧侧脑室增宽,MRA未见异常;双侧筛窦、左侧额窦、上颌窦和蝶窦炎症。
电生理学检查
心电图
未见异常。
脑电图
未见异常。
肌电图
左肱二头肌、右外展小指肌、右胫前肌示神经性损害,结合其右正中神经、右尺神经感觉传导速度正常、波幅低,考虑周围神经轴索损害可能性大。
神经心理学
分别采用韦氏成人智力量表(WAIS-RC)、Zung量表和HAMILTON焦虑量表进行评分。言语量表总分36分,Zung量表总分37分,HAMILTON焦虑量表:焦虑的精神症状8分,焦虑的躯体症状4分。受试结果:受试者智商为72,属于“边界”范围,其中言语智商为68,属于“智力缺损”范围,操作智商为82,属于“低常”范围。自身比较:受试的操作智商比言语智商好,差异有显著性。患者无焦虑和抑郁表现。
入院诊断
定位:锥体外系。
定性:遗传变性。
初步诊断:舞蹈病-棘红细胞增多症。
经确诊后,给予口服氟哌啶醇2mg,每日三次;维生素E 0.2g,每日三次;维生素AD丸1片,每日三次。治疗1周后,患者口周和肢体不自主运动基本消失,咬舌、咬唇、流涎明显改善,吞咽功能明显好转,构音障碍略有好转,面部红斑经外用皮康霜治疗后明显减少,出院后继续服药并随访。